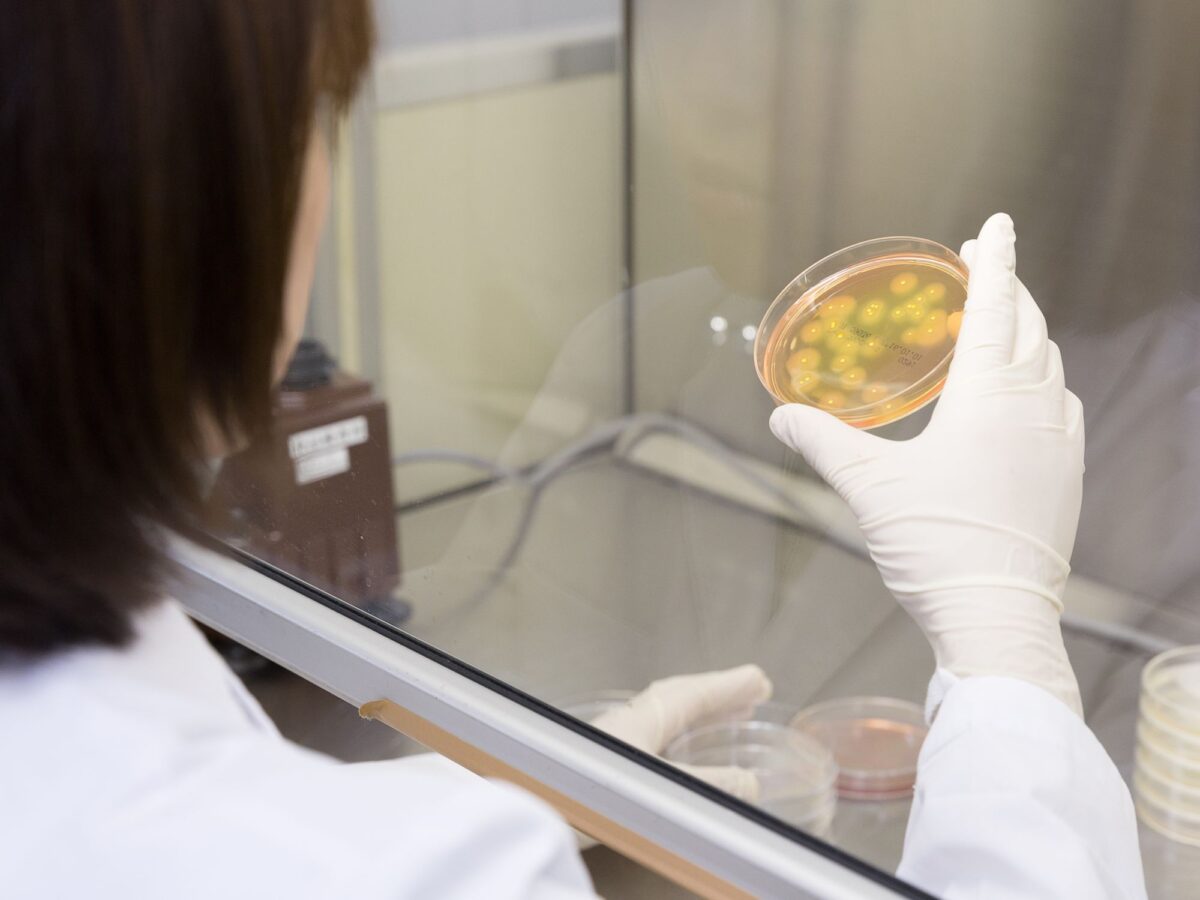

異物・付着物などの組成や構造を分析することで
原因と混入経路の特定ができ再発防止へ
品質管理やクレーム対応などお客様の問題解決をサポートします
POINT1
最先端の分析装置と豊富な経験・実績を活かした
解決方法のご提案
POINT2
数mmサイズでも分析可能!(分析項目による)
材料などの製品から食品中の異物まで幅広く分析可能
異物分析について
異物分析とは、製品や食品に混入・付着した異物が何であるかを組成や構造分析により特定し、混入原因の究明や再発防止につなげるための分析・調査です。
異物や付着物によるお困りごとがございましたら、ぜひ弊社の異物分析をご活用ください。
ご依頼例)
- 製品に異物が混入しており、クレームがあった
- 製品に発生した不具合原因を調べたい(変色、破損、ふくれ、塗装不良など)
- 製品・ロット間の性状を比較したい
- 配管から黒い異物が出てくる
- 屋根の白色付着物が何か知りたい など
食品製造業のお客様へ
参考:食品の異物混入の実態
- 「全国における食品への異物混入被害実態の把握」(厚労省)の調査報告より『約3年間の異物混入事例の苦情件数は、14,684件の報告あり』
⇒ 全国にて、年間4,895件もの異物混入による苦情が発生しています - 要因別苦情件数(東京都保険医療局 R5年度:全4,650件)
⇒異物混入は、食中毒に続き苦情の上位要因であるため、異物混入対策を行うことが重要となります

ご依頼の流れ

①ご相談(お客様へのヒアリング)
まずは、弊社スタッフへご相談ください。異物の形状や色、発生した状況、発生時期・頻度、周辺の環境などの情報をお伺いいたします。
異物の写真がございましたらご提供頂けると状況が把握しやすく、解決への手がかりとなります。
また、対照品(正常品)のご提供も異物解析の手助けになります。
②サンプル送付
ご相談内容を元に分析方法をご提案させて頂き、サンプルの送付方法をご説明いたします。
(注意:送付の際、異物に直接粘着テープを貼らないようお願いいたします。異物表面に付着した粘着成分を分析してしまい、誤った解析結果となる可能性があります。)
③異物分析
各分析装置の特色を活かし、組み合わせて分析を行うこともございます。
顕微鏡観察・物性確認
サンプル到着後、まず最初に異物の外観観察を行います。
顕微鏡を用いて異物部位の拡大観察を行い、その異物の形状や色、付着状況などの確認を行います。この外観観察は、その後の分析内容を決める重要な要素となります。
必要に応じて異物の性状(pH、水溶性、脂溶性、硬さ、弾力性など)を確認します。

無機物定性分析
外観観察の結果、鉱物、金属片、結晶物など無機物系の異物であることが予想された場合、走査電子顕微鏡エネルギー分散型X線分析装置(SEM-EDS)などで元素分析を行います。
異物に含まれる元素情報を調べることにより、金属やガラスなどの材質を推定することができます。
その他、ICP質量分析装置(ICP-MS)にて水溶液中の元素分析や、X線回折装置(XRD)にて構造解析を行うなど異物の性状により適切な装置を使用します。

有機物定性分析
外観観察の結果、樹脂、ゴム、繊維、食品由来など有機物系の異物であることが予想された場合、フーリエ変換赤外分光光度計(FT-IR)などを用いて物質の化学構造や組成の確認を行います。
装置内のライブラリ情報やリファレンスサンプル(対照品、混入の可能性が疑われるものなど)の測定により、異物の主成分を推定することができます。

細菌培養
外観観察の結果、カビなど微生物系の異物であることが予想された場合、各種細菌培養を行います。
④報告書送付
結果が出た段階で電話もしくは速報をお送りいたします。報告書の内容をお客様にご確認頂いた後、ご不明点等が無ければ報告書原本を送付いたします。
結果に基づき、追加分析のご提案をさせて頂く場合もございます。
分析事例
事例① 弁当中に細長い糸のようなものが混入していた。髪の毛か?
⇒顕微鏡観察時に毛髄質が見られなかった。また有機物定性分析の結果より、異物はたわしのデータと類似していることが分かった。

事例② 喫食中に口の中で異物を感じた。
⇒顕微鏡観察時に金属の光沢が見られた。また無機物定性分析の結果より、異物の元素組成が分かった。

お問い合わせ
お電話またはメールよりお気軽にお問い合わせください。
TEL:0748-32-5001
Mail:online@hiyoshi-es.co.jp
(担当者:後藤、奥長)
